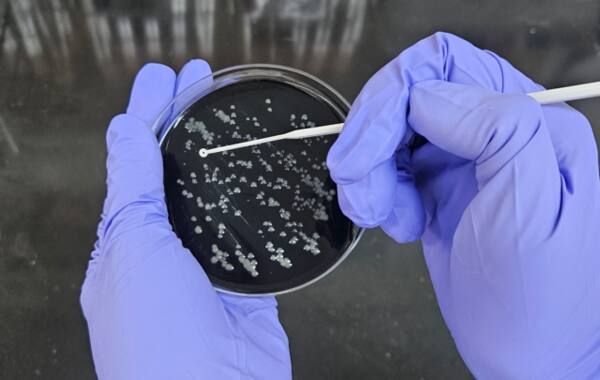
레지오넬라균 환경검사. 인천시 제공

인천 동구는 레지오넬라증 감염병 예방을 위해 최근 대형 건물, 종합병원, 쇼핑센터 등 다중이용시설 6곳에서 27개의 검체를 채취해 수질검사를 의뢰했다고 21일 밝혔다.
레지오넬라증은 건물 냉각탑이나 샤워기 등의 수계시설에서 생기는 물입자가 에어로졸(공기 중 고·액체 상태 입자로 0.001∼100 ㎛) 형태로 호흡기로 들어가 생기는 3급 법정 감염병이다. 증상은 일반 감기와 비슷하지만 만성 폐질환자나 면역저하자에게는 폐렴까지 일으킬 수 있는 것으로 알려져 있다.
구는 감염병 예방 차원에서 에어컨 가동이 많은 여름철 환경 검사를 하고 있다. 또 전문 검사 기관에서 검사 뒤 레지오넬라균을 검출한 시설에 대해 즉시 소독 및 재검사 조치등 적절한 관리 여부를 확인할 예정이다.
김찬진 동구청장은 “각 시설에 냉각탑등의 주기적인 소독과 관리의 중요성에 대해 다시 알리고, 감염병 예방을 위해 최선을 다하겠다”고 말했다.
Copyright ⓒ 경기일보 무단 전재 및 재배포 금지
본 콘텐츠는 뉴스픽 파트너스에서 공유된 콘텐츠입니다.



